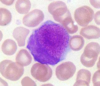

Special Species Exam I Material Flashcards
(141 cards)
What is the causative agent of “wet tail” in hamsters?

Lawsonia intracellularis
This is a chinchilla penis.
What’s the arrow pointing to?

fur ring
- Fur surrounding base of penis can accumulate and form a constricting ring
- Clinical Signs: stranguria, excessive grooming of prepuce –> paraphimosis or inflammation of penis (possible emergency).
- Treatment: sedate and remove, 50% dextrose and lube to reduce swelling and replace penis
This leukocyte is unique to the guinea pig. What is it called?
Kurloff Cell
- Origin is controversial
- Highest concentration in pregnant females
- Thought to play a role in creating a physiological barrier between fetus/mother
What animals transmit monkey pox?
Gambian Giant Rat and Prairie Dogs

How is rabbit tularemia transmitted?

Deer tick, brown dog tick, Lone star tick
Also biting flies, or contact with contaminated animals and material, poorly cooked meat, aerosol transmission (*possible biological warfare)
This viral disease in ferrets produces profuse, mucoid, green slime diarrhea; lethargy, dehydration, and anorexia:
Epizootic Catarrhal Enteritis (ECE)
- Epizootic catarrhal enteritis (enteric coronavirus)
- Older animals susceptible, young are carriers
- Profuse, mucoid, green slime diarrhea; lethargy, dehydration, anorexia
- Mortality low with treatment
- Antibiotics for secondary infection
Oh snap! What’s going on with these rabbit feet?

pododermatitis
- “Sore hocks”, avascular necrosis of plantar surface of rear feet
- Predisposing factors: obesity, lack of exercise, housing (wire, metal grate, concrete, carpet), breed (Rex)
- Txt: relieve pressure on affected area
- Non-abrasive, dry surface such as rubber, towels, newspaper, antibiotics, analgesics
Name the treatments that are generally effective with ‘snuffles’ in rabbits:
Generally responsive to chloramphenicol, novabiocin, oxytetracycline, penicillin G, fluroquinolones, TMS
Choose antibiotic with rabbit GI flora in mind
T/F: Mast cell tumors in ferrets commonly metastasize
False
- Mast cell tumors and basal tumors are only common in the skin of ferrets, and don’t typically metastasize.*
- They can be itchy, bleed, and appear ulcerated; can be removed surgically if needed - prognosis is good*
T/F: Ferrets that survive the respiratory phase of canine distemper typically succumb to the neurologic stage within several weeks
True

T/F: Bacillus, Bacteroides, small numbers of E. Coli, protozoa, yeasts, and Clostridium are all normal flora of the rabbit cecum
True

T/F: Rabbits produce “night stools” or cecotropes, which look somewhat like diarrhea but actually a good source of B vitamins, VFAs and amino acids.
True

What is the most common cutaneous tumor of guinea pigs?
Trichofolliculoma
Benign, on dorsum, round and hairless

What is the treatment protocol for rabbit spirochetosis (“rabbit syphylis”)?

long acting penicillin
Procaine+ Benzathine Pen G or Combi-pen, give 2 SQ doses 4 days apart
-
Spirochetosis - “Rabbit Syphilis” (aka Vent Disease)
- Treponema canuculi venereal from doe to kit during parturition.
- Dz of young rabbits à scabs on nose and vent.
- Dx: Biopsy, PCR, treatment response
- Tx: Long acting penicillin injection – Procaine + Benzathine Pen G or Combi-pen, give 2 SQ doses 4 days apart

This urogenital disease in guinea pigs is the result of negative energy balance & fat metabolism during the last two weeks of gestation:
pregnancy toxemia
- CS: anorexia, lethargy, dyspnea, death
- Treatment: nutritional support – critical care diet
- Prognosis guarded
How does myxomatosis manifest in Sylvilagus species of rabbits?
In Sylvilagus species, manifests as a benign tumor at site of viral entry (typically ear base)
- Rabbit Myxomatosis (rabbit pox) – very deadly to rabbits, transmitted through arthropods
- Australia introduced this to the rabbit population to cull them “rabbit bioweapon”
- CS: lethargy, fever, anorexia, skin hemorrhages. Swelling around eyes and ear base
- In Sylvilagus species, manifests as a benign tumor at site of viral entry (typically ear base)
- Dx: CS, histopath of infected tissue and virus isolation
Canine distemper can be fatal in ferrets. What is the general treatment protocol?

no treatment
There is no treatment, so must vaccinate at 6, 10, 14 weeks old and annually
On histopathology, eosinophilic viral inclusion bodies (intracytoplasmic and intranuclear) were found in the bladder of a ferret. What is the most likely diagnosis?

canine distemper
Clinical signs: anorexia, pyrexia, chin dermatitis, photophobia, nasal or ocular discharge, brown crusts of face
T/F: Uterine adenocarcinoma is the most common neoplasia in rabbits, however it metastasizes slowly and can be cured with ovariohysterectomy
True

This occurs in prairie dogs when the root of an incisor enlarges to the point that the nasal passages become blocked, causing difficulty breathing:
odontoma

Name the mite in hamsters and gerbils that is zoonotic:
Liponyssoides sanguineus
- (house mouse mite)*
- Not common, but can bite humans and transmit Rickettsia akari (rickettsial pox)*

These neoplasias in ferrets originate from original notochord:

Ferret Chordomas
- Originate from original notocord
- Round, smooth, firm masses that develop on the tail tip
- Slow growing, but can metastasize
- Txt: surgical removal (tail amputation)
What is the etiological agent associated with Tyzzer’s Disease?
Clostridium piliforme
-
Tyzzers (gerbils, hamsters, mice)
-
Tyzzer’s disease – Clostridium piliforme
- “pick-up sticks” on pathology
- Clinical signs – death, dehydration, unkempt, diarrhea, etc.
- Diagnosis – often at necropsy with necrotic hepatic foci and intestinal lesions
- Predetermining factors – over crowding, poor sanitation, over heating, parasites, poor diet
- Treatment – supportive
-
Tyzzer’s disease – Clostridium piliforme

How do you diagnose urinary tract calculi in rabbits?
radiographs or ultrasound
-
Urinary Tract Calculi:
- Calculi and large amounts of calcium carbonate (urine sludge)
- Signs: calciuria with anorexia, dysuria, stranguria, hunched posture, perineal staining with calcium carbonate precipitate, reluctance to move
- DDx: bladder sludge without calculi, infectious cystitis
- Dx: radiographs or US
- Tx: SQ fluid diuresis, flush bladder (anesthesia) until urine is clear, or cystotomy with culture and stone analysis.
- May commonly recur: increase fluid consumption, change diet to decrease alfalfa (high in Ca2+)
























































